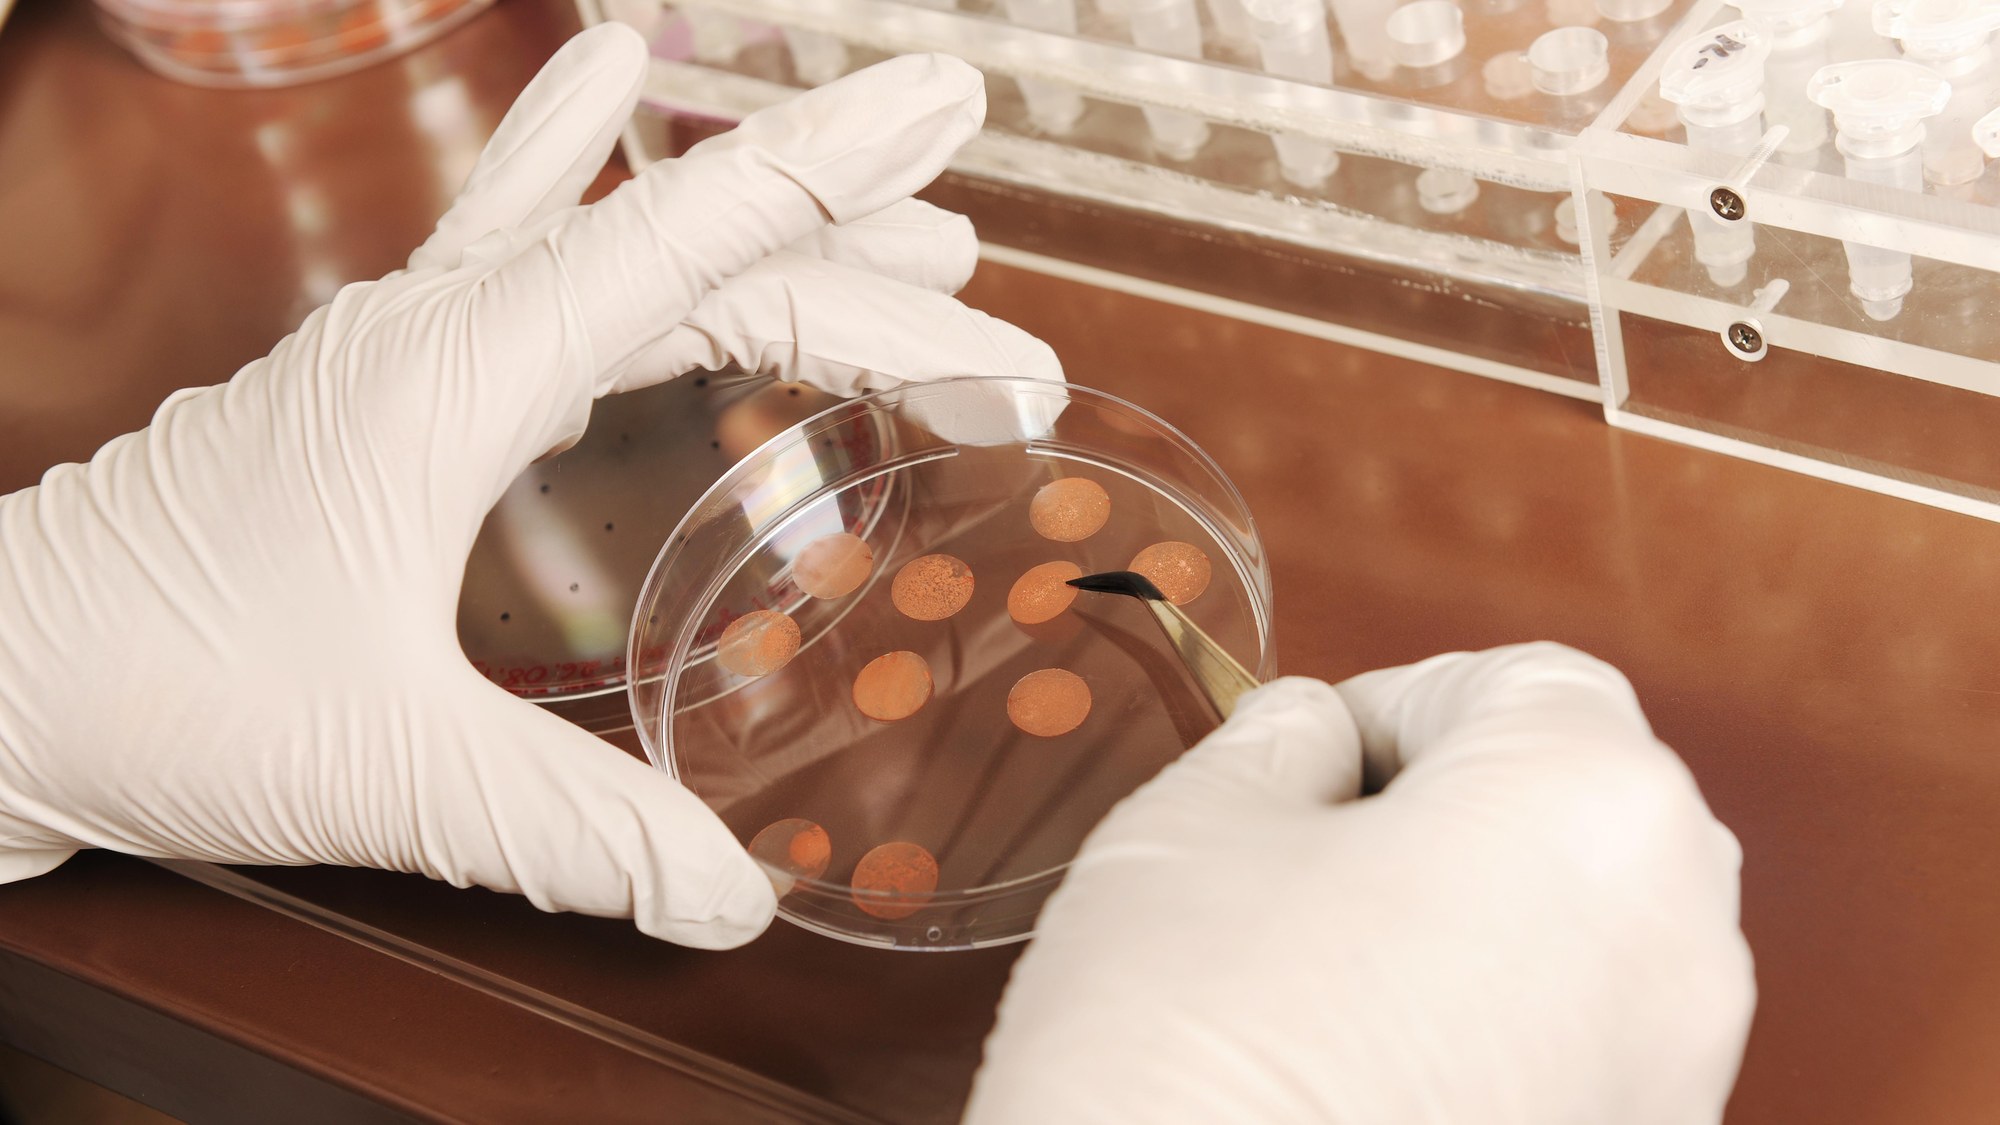

Vorbereitungen für den Versuch im All
Vorbereitungen für den Versuch im All
Im Labor des Deutschen Zentrums für Luft- und Raumfahrt (DLR) werden die Proben für die Versuche BIOMEX und BOSS vorbereitet. Die Organismen sollen in der Anlage EXPOSE-R2 an der Außenseite der Internationalen Raumstation ISS den Weltraumbedingungen ausgesetzt werden.